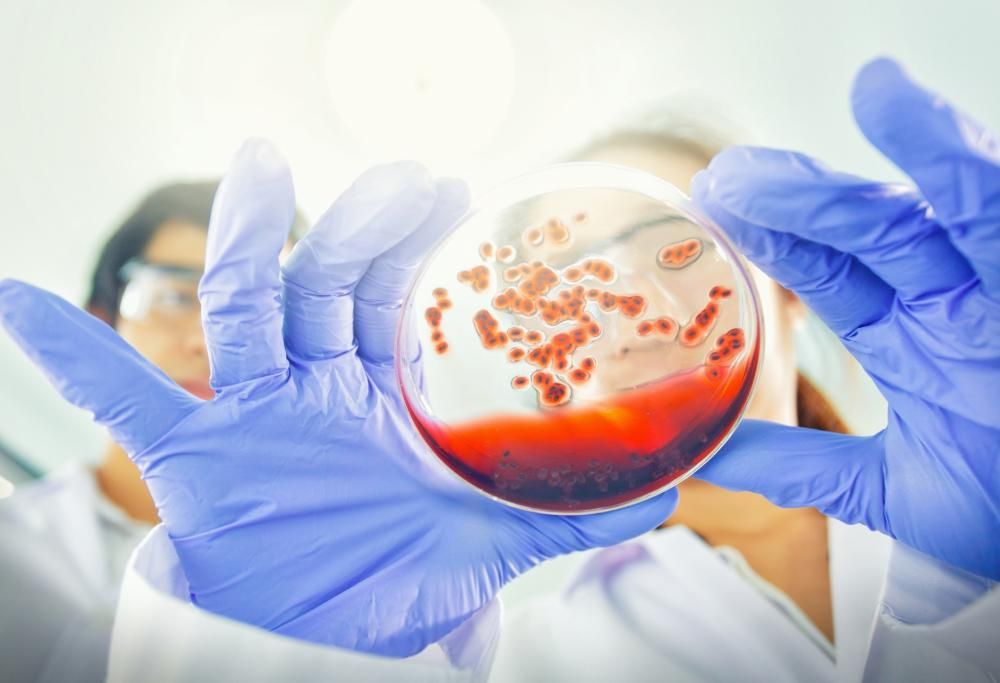

I primi segni di tumore individuati con un esame del sangue: lo studio italiano
Questo esame si basa sulle analisi del DNA per la diagnosi superprecoce.
26 Settembre 2019
Uno studio pubblicato su Cell Death & Desease e realizzato da un’equipe internazionale di esperti, coordinato dai ricercatori di Bioscience Genomics, con la partecipazione dell’Università degli Studi di Roma Tor Vergata, ci fornisce una nuova speranza per la cura dei tumori, o meglio, per la diagnosi precoce, fattore che comporta maggiori possibilità di sopravvivenza.
Il test messo a punto da questo team di ricercatori potrebbe consentire di individuare i primi segni del tumore con una semplice analisi del sangue, prima ancora che la malattia inizi a manifestarsi. La ricerca si basa su un algoritmo brevettato da Bioscience che utilizza il sequenziamento del DNA per l’individuazione delle alterazioni genetiche che precedono lo sviluppo del cancro in persone sane e asintomatiche.
Durante la ricerca sono stati analizzati per un periodo da 1 a 10 anni campioni di sangue prelevati da 114 individui inizialmente tutti sani. “Si tratta di un primo importante passo nella strada verso una rapida applicazione clinica della genomica in oncologia – afferma, come riporta Ansa, Giuseppe Novelli, rettore dell’Università Tor Vergata e responsabile dello studio – Ora sappiamo di avere a disposizione una solida tecnologia che permetterà il passaggio dal laboratorio alla pratica”.


















